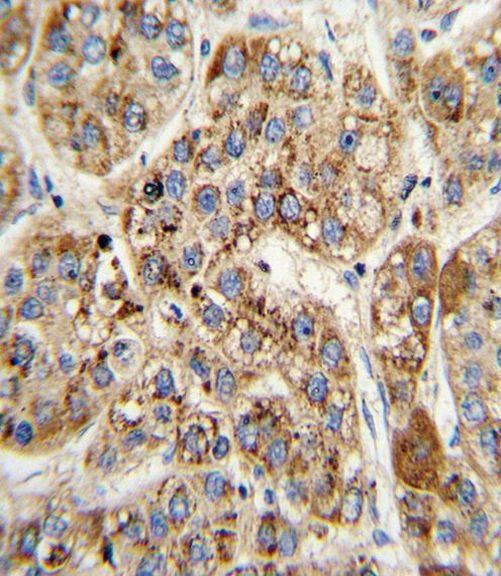
MCCC2 Antibody in Immunohistochemistry (Paraffin) (IHC (P))
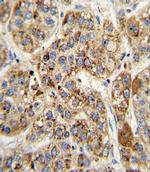
MCCC2 Antibody in Immunohistochemistry (Paraffin) (IHC (P))

Search
Invitrogen
MCCC2 Polyclonal Antibody
{{$productOrderCtrl.translations['antibody.pdp.commerceCard.promotion.promotions']}}
{{$productOrderCtrl.translations['antibody.pdp.commerceCard.promotion.viewpromo']}}
{{$productOrderCtrl.translations['antibody.pdp.commerceCard.promotion.promocode']}}: {{promo.promoCode}} {{promo.promoTitle}} {{promo.promoDescription}}. {{$productOrderCtrl.translations['antibody.pdp.commerceCard.promotion.learnmore']}}
产品信息
PA5-35323
宿主/亚型
分类
类型
抗原
偶联物
形式
浓度
保存条件
运输条件
RRID
靶标信息
COX3 is a multi-pass membrane protein. It belongs to the cytochrome c oxidase subunit 3 family. Defects in COX3 are a cause of Leber hereditary optic neuropathy (LHON) and cytochrome c oxidase deficiency (COX deficiency). Defects in MT-CO3 are also found in mitochondrial encephalomyopathy with lactic acidosis and stroke-like episodes (MELAS) syndrome and recurrent myoglobinuria.
仅用于科研。不用于诊断过程。未经明确授权不得转售。